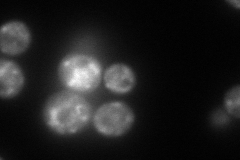
YDR238C
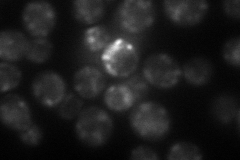
YDR238C
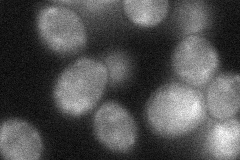
YDR238C
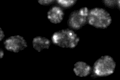
YDR238C

View description
Essential beta-coat protein of the COPI coatomer, involved in ER-to-Golgi protein trafficking and maintenance of normal ER morphology; shares 43% sequence identity with mammalian beta-coat protein (beta-COP)
Localization:
Intensity:
Fold change:
Significance:
-
C’ GFP library in SD

punctate139.85 -
N' NOP1pr-GFP in SD
punctate131.962 -
N' TEF2pr-mCherry in SD
punctate63.4107 -
N' NATIVEpr-GFP in SD

punctate,vacuole57.5417 -
N' TEF2pr-VC and Cyto-VN in SD
punctate37.2148 -
C’ GFP library in SD+DTT
punctate169.821.21No -
C’ GFP library in SD+H2O2

punctate143.771.02No -
C’ GFP library in Starvation Media

punctate148.451.06No -
C’ GFP library on the background of Pup2-DaMP

punctate -
C’ GFP library on the background of CCT mutant

punctate146.2011.04533No
